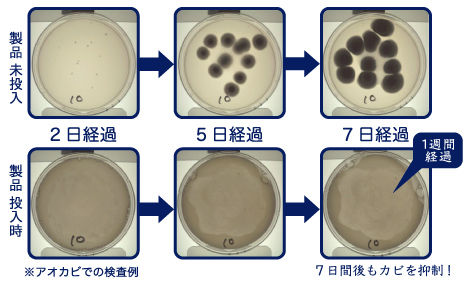

top of page
SHELLASHは何に効く?
①除菌抗菌
「貝殻焼成カルシウム」の強アルカリ性が細胞膜を通過し、ウィルスなどのタンパク質からできる細胞質を加水分解することで除菌効果が発揮されます。また、原料そのものに次亜塩素酸系の製品より持続性の高い抗菌効果があることが確認されています。

②様々な菌に効果的

(※全てのウィルス・菌・カビに効果を発揮する訳ではありません。使用する環境で効果の違いもあります。)
SHELLASHは強アルカリの性質が特徴です。その性質を活かし、他の天然素材を使用した抗菌剤と比べ非常に有効的なダメージを菌やウィルスに与えます。幅広いウィルス・細菌に対しても有効に働きエンベロープ・ノンエンベロープどちらのウィルスにも高い効果を発揮します。一般的な塩素系の除菌剤と比べ効果は同等ですが、SHELLASHの原料である「貝殻焼成カルシウム」の除菌効果には高い持続性があります。天然成分ですがしっかり除菌効果があります。
③抗カビ効果
公的機関での検査の一例では、黒カビ、コウジカビ、アオカビの繁殖を抑制する効果が確認されています。お掃除後にエアコンの吹き出し口、浴室内の壁面や天井にスプレーすることで一定期間しっかりと抗カビの効果も得られます。カビが繁殖しやすい高温多湿でジメジメとした日本の環境で効果的です。
※カビ取り剤ではありません。カビの発生を抑制する効果があります。
〈試験方法〉
(1)ポテトデキストロース培地 注)に、貝殻焼成カルシウム粉末を所定量加える。
注)精製水にポテトエキス、ブドウ糖、寒天を加えたもので、カビを試験的に旺盛に繁殖させるための培地
(2)小分けしたシャーレ(約20ml)にカビ胞子を約10個植え付け。
(3)室温にて養生し、経時的にカビの繁殖を目視観察。
SHELLASHはオホーツク海産のホタテ貝の貝殻を1000度以上の高温で焼成後(焼き上げた後)に加水し生成されます。これが水に溶けることでPH11.5〜13前後の強アルカリ水になります。この強アルカリ性がウィルスや食中毒の原因とされる菌などの細胞膜部分に含まれるタンパク質を破壊し除菌効果を発揮します。また、食材表面の水では落ちにくい汚れ・ワックス・防腐剤などを洗浄・除去します。除菌に加え抗カビ効果も作用するので、食材の酸化を抑制し野菜・果物・肉・魚など食材の鮮度を保持し日持ちを向上させます。また、キッチン用品、子供用玩具、ペット用品、トイレ、浴室などと幅広い場面で除菌・抗カビの働きが役立ちます。
bottom of page